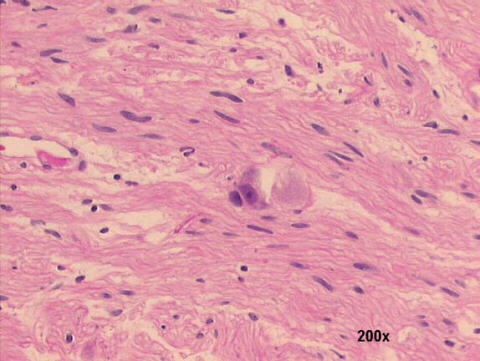

Cytologic features of Ganglioneuroma Cellular patterns: |
In this case we found many mature ganglion cells and a fibrillar stroma with interlaced Schwann (fiber-like) cells. Both the Papanicolaou and MGG cytology images (use the Back command of your browser to review these images) show the large ganglion cells, with their abundant granular cytoplasm, and the large nucleolus in their eccentric nuclei. Free cigar-shaped nuclei in the background are probably from the Schwann cells. The differential diagnosis of retroperitoneal ganglioneuromas is with ganglioneuroblastomas, that show a misture of neuroblasts and ganglion cells, and with peripheral nerve sheath tumors when ganglion cells are not present in the aspirate.


Hospital de Clinicas de Porto Alegre, Pathology
& Cytopathology Laboratories
Porto Alegre,
RS Brazil
